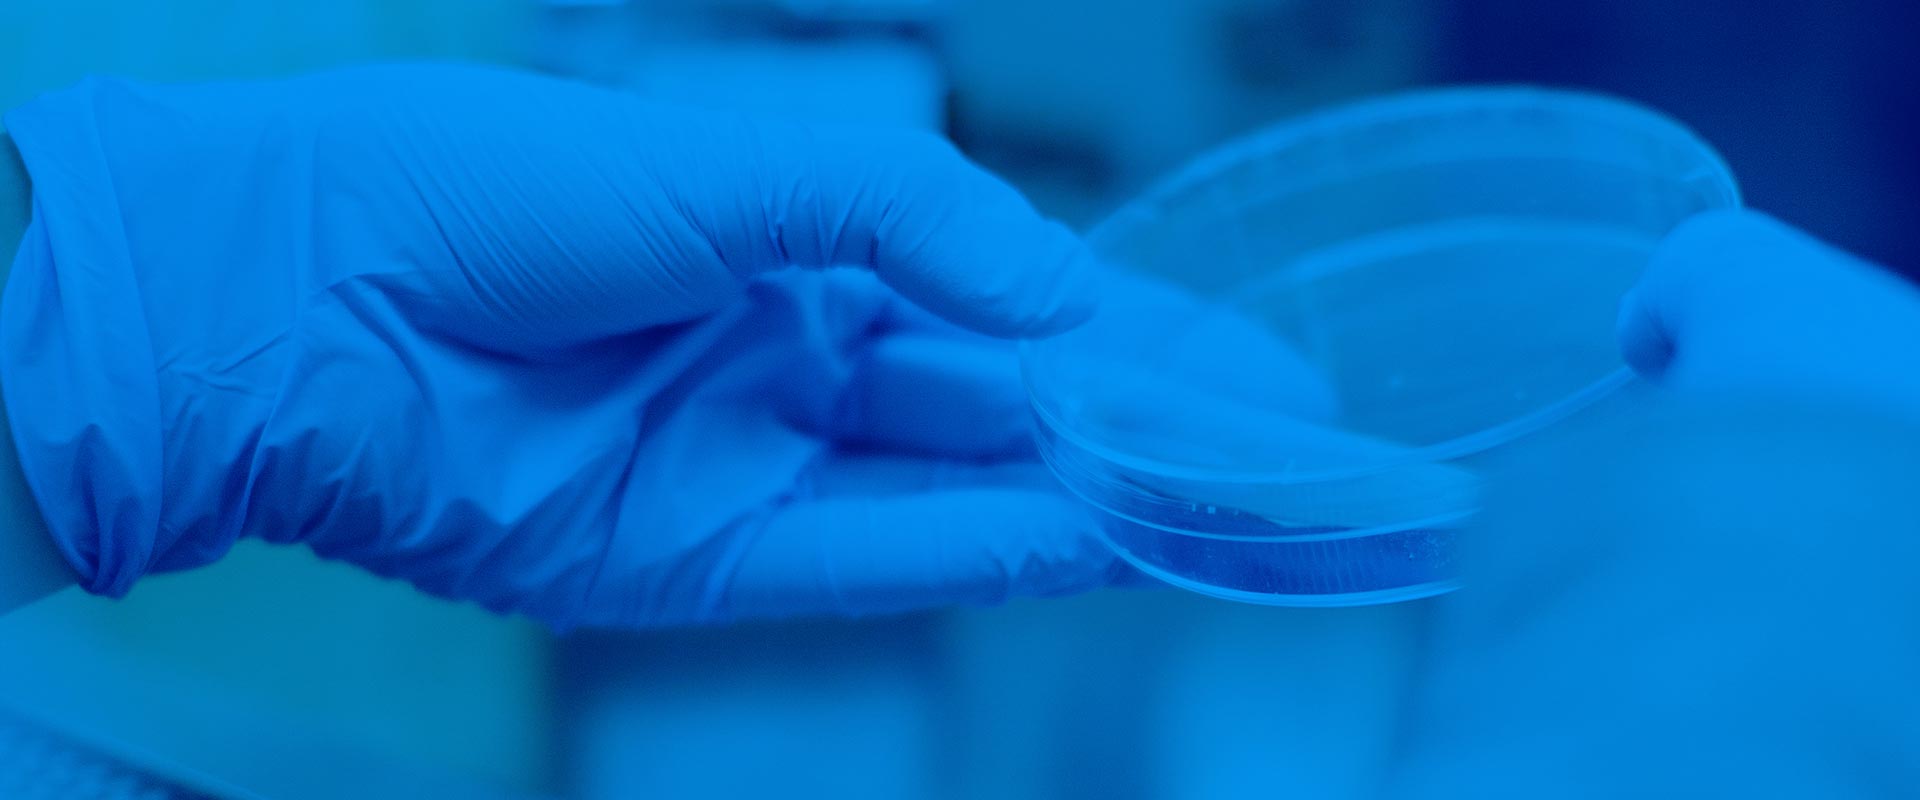

-
 We Care About Your HealthMedical Services That
We Care About Your HealthMedical Services That
You Can Trust -
 We Care About Your HealthYour Health, Our Priority!
We Care About Your HealthYour Health, Our Priority!

Welcome to NIMS Hospital
We National Institute Of Medical Science at Sector 23 is dedicated for providing treatments for many ailments which can not be cured easily. We provide complete care to patients of all age groups. It is our aim to treat as many patients as we can by providing suitable treatments. We also provide suitable medicines according to the disease and disorders along with treatment which are made with precision and utmost care by professionals.
More Details